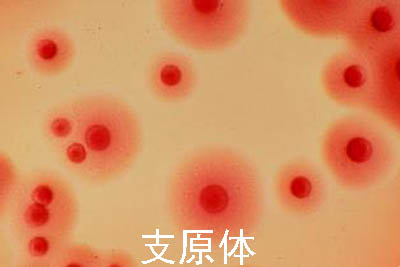

支原体感染危害大吗?
作者:未知 点击:0 次
2022-01-08 21:00:10
现在青年人中很多很多的前列腺炎都和支原体、衣原体感染有很大的关系。如果这时候还没有经过治疗,衣原体、支原体感染还可以逆行感染到肾脏引起肾炎,对男性是这样的。
对女性它的感染途径除了泌尿系统和男性相比较差不多,但是女性没有前列腺,没有睾丸、附睾,它一般出现的症状,比如说在尿道,就是尿道不舒服的感觉,尿道的酸胀,有的时候有点疼痛,有的时候有点灼热、搔痒的感觉,但是这种感觉比较轻微。
女性的症状主要还是出现在宫颈,我们叫宫颈炎,衣原体、支原体性的宫颈炎,或者叫非淋菌性的宫颈炎。宫颈炎的症状一般都是,我们看患者一般白带比较多一点,有的时候有点异味,这个白带比较粘稠一些,有的时候有性交的出血,过了性生活以后会出血,或者性交的时候有疼痛的感觉,因为她阴道有炎症,宫颈有炎症,性交的时候就会疼痛。看她宫颈一般比较红,伴发宫颈糜烂,宫颈口有一种分泌的黏液,一般比较清晰,附着在宫颈口,比较多。
武汉李小平中医温馨提醒:这就是我们常见的一般的衣原体、支原体引起的泌尿生殖系统感染的症状。我们看到这些症状我们只能怀疑这是衣原体、支原体引起的,我们确证就需要做有必要的化验检查。化验检查我们常用的检查衣原体、支原体通过免疫荧光,免疫种化的方法进行,支原体通过培养的方法进行,这个在大的医院都是可以进行的,衣原体大概40分钟左右就可以出现结果,其中的一项或者其中的两项是阳性,我们就认为它是衣原体、支原体的感染,我们可以诊断非淋菌性尿道炎,也可以叫支原体、衣原体,或者叫衣原体支原体性的泌尿生殖系的感染。
推荐阅读:
相关文章











